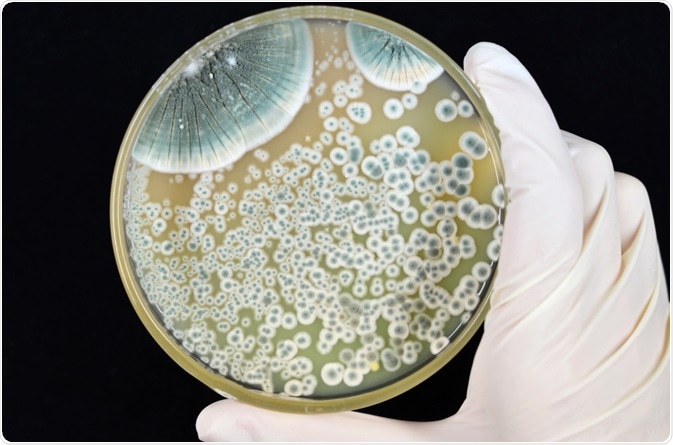

The beta-lactam antibiotic penicillin represents one of the predominantly used antibiotics for the treatment of infectious diseases. It is produced as an end product by certain filamentous fungi, most notably of which includes Penicillium chrysogenum. Although discovered in 1928, the biosynthesis pathways leading to penicillin were elucidated much later.
Image Credit: Kallayanee Naloka / Shutterstock.com
Researchers from the Massachusetts Institute of Technology (MIT) continued to work on the problem of the chemical and biosynthesis of penicillin, despite the fact that the structure has been completely worked out and mass production of the drug by fermentation processes was quick. In 1957, these MIT researchers finally achieved total synthesis of natural penicillin.
Three steps of penicillin biosynthesis
Penicillin biosynthesis is often divided into three important steps. The first catalytic step is mediated by delta-(L-alpha-aminoadipyl)-L-cysteinyl-D-valine synthetase, otherweise known as ACV synthetase, which is a high molecular mass enzyme that condenses three leading amino acids of L-alpha-aminoadipate, L-cysteine, and L-valine, into the tripeptide ACV.
In the second step, oxidative ring closure of the linear tripeptide results in a formation of a bicyclic ring, i.e., the four-membered beta-lactam ring fused to the five-membered thiazolidine ring that is characteristic for all penicillins. The enzyme employed in this step is isopenicillin N synthase, and the resulting compound is isopenicillin N (IPN), which has weak antibiotic activity, making it the first bioactive intermediate of penicillin biosynthesis pathway.
At this point, the pathway can diverge for the different microorganisms. In the case of Penicillium, as well as the other penicillin-producing fungi, the third step represents the exchange of the lateral chain of L-alpha-aminoadipate by a hydrophobic lateral chain. Comparatively, in the genus Acremonium, isopenicillin N is converted into penicillin N via a two-enzyme system that involves both acyl-CoA-synthetase and acyl-CoA-racemase.
Genetics of biosynthesis
The genes for beta-lactam antibiotic biosynthesis are found clustered both in filamentous fungi and bacteria. Their organization is common to all beta-lactam producers, which includes the genes pcbAB for ACV synthetase and pcbC for ACV cyclase. Such linkages of antibiotic-biosynthesis genes is a well-described phenomenon in a myriad of antibiotic-producing organisms.
The expression of genes of the penicillin cluster is controlled by pleitropic regulators including LaeA, which is a methylase that is involved in heterochromatin rearrangement. Furthermore, repressors like AnBH1 and VeA are also involved in the regulation.
Key enzymatic steps in penicillin biosynthesis are confined to only two compartments including the cytosol and microbody. Using subcellular fractionation and immuno-electron microscopy, ACV synthetase was localized in the cytosol, together with isopenicillin N synthetase. Comparatively, some of the enzymes pivotal for the third step of penicillin biosynthesis are localized in microbodies.
Penicillin biosynthesis genes are controlled by a complex regulatory network that is influenced by various factors such as ambient pH, carbon source, amino acids, nitrogen levels and much more. All of the aforementioned investigations have contributed significantly to the elucidation of the signals leading to the production of penicillin, and thus can be expected to have significant impact on rational strain improvement programs.
References
Further Reading
Last Updated: Feb 17, 2023